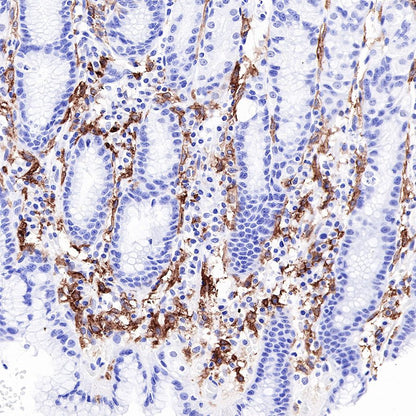

IHC shows positive staining in paraffin-embedded human stomach. Anti-CD16a antibody was used at 1/1000 dilution, followed by a HRP Polymer for Mouse & Rabbit IgG (ready to use). Counterstained with hematoxylin. Heat mediated antigen retrieval with Tris/EDTA buffer pH9.0 was performed before commencing with IHC staining protocol.
Product Details
Product Details
Product Specification
| Host | Rabbit |
| Antigen | CD16a |
| Synonyms | IgG Fc receptor III-A, CD16-II |
| Immunogen | N/A |
| Location | Secreted, Cell membrane |
| Accession | P08637 |
| Clone Number | SDT-R099 |
| Antibody Type | Rabbit mAb |
| Application | IHC-P |
| Reactivity | Hu |
| Purification | Protein A |
| Concentration | 0.25 mg/ml |
| Physical Appearance | Liquid |
| Storage Buffer | PBS, 40% Glycerol, 0.05% BSA, 0.03% Proclin 300 |
| Stability & Storage | 12 months from date of receipt / reconstitution, -20 °C as supplied |
Dilution
| application | dilution | species |
| IHC-P | 1:1000 | null |
Background
CD16 is known as low affinity IgG receptor III (FcγRIII). It is expressed as two distinct forms (CD16a and CD16b). CD16a (FcγRIIIA) is a 50-65 kD polypeptide-anchored transmembrane protein. It is expressed on the surface of NK cells, activated monocytes, macrophages, and placental trophoblasts in humans. CD16b (FcγRIIIB) is a 48 kD glycosylphosphatidylinositol (GPI)-anchored protein. Its extracellular domain is over 95% homologous to that of CD16a, and it is expressed specifically on neutrophils. CD16 binds aggregated IgG or IgG-antigen complex which functions in NK cell activation, phagocytosis, and antibody-dependent cell-mediated cytotoxicity (ADCC).
Picture
Picture
Immunohistochemistry


IHC shows positive staining in paraffin-embedded human liver. Anti-CD16a antibody was used at 1/1000 dilution, followed by a HRP Polymer for Mouse & Rabbit IgG (ready to use). Counterstained with hematoxylin. Heat mediated antigen retrieval with Tris/EDTA buffer pH9.0 was performed before commencing with IHC staining protocol.

IHC shows positive staining in paraffin-embedded human spleen. Anti-CD16a antibody was used at 1/1000 dilution, followed by a HRP Polymer for Mouse & Rabbit IgG (ready to use). Counterstained with hematoxylin. Heat mediated antigen retrieval with Tris/EDTA buffer pH9.0 was performed before commencing with IHC staining protocol.

IHC shows positive staining in paraffin-embedded human lung. Anti-CD16a antibody was used at 1/1000 dilution, followed by a HRP Polymer for Mouse & Rabbit IgG (ready to use). Counterstained with hematoxylin. Heat mediated antigen retrieval with Tris/EDTA buffer pH9.0 was performed before commencing with IHC staining protocol.

IHC shows positive staining in paraffin-embedded human hodgkin's lymphoma. Anti-CD16a antibody was used at 1/1000 dilution, followed by a HRP Polymer for Mouse & Rabbit IgG (ready to use). Counterstained with hematoxylin. Heat mediated antigen retrieval with Tris/EDTA buffer pH9.0 was performed before commencing with IHC staining protocol.

IHC shows positive staining in paraffin-embedded human NK/T cell lymphoma. Anti-CD16a antibody was used at 1/1000 dilution, followed by a HRP Polymer for Mouse & Rabbit IgG (ready to use). Counterstained with hematoxylin. Heat mediated antigen retrieval with Tris/EDTA buffer pH9.0 was performed before commencing with IHC staining protocol.

IHC shows positive staining in paraffin-embedded human hepatocellular carcinoma. Anti-CD16a antibody was used at 1/1000 dilution, followed by a HRP Polymer for Mouse & Rabbit IgG (ready to use). Counterstained with hematoxylin. Heat mediated antigen retrieval with Tris/EDTA buffer pH9.0 was performed before commencing with IHC staining protocol.